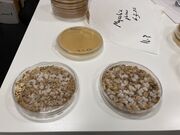

File list
Jump to navigation
Jump to search
This special page shows all uploaded files.
| Date | Name | Thumbnail | Size | User | Description | Versions |
|---|---|---|---|---|---|---|
| 14:59, 18 June 2022 | Trio.JPG (file) |  |
2.14 MB | Rachel | Shannon, Rachel, and Laura prepare to get first samples | 1 |
| 14:56, 18 June 2022 | SVTlaunchday.jpeg (file) |  |
4.87 MB | Rachel | 1 | |
| 16:04, 14 June 2022 | Mitch7.png (file) |  |
447 KB | Rachel | announcement for workshops | 1 |
| 16:27, 8 June 2022 | Samplingsites.png (file) |  |
333 KB | Rachel | Montreux Bay sites for water quality monitoring | 1 |
| 16:05, 7 June 2022 | Riverplus.JPG (file) |  |
1.35 MB | Rachel | 1 | |
| 15:57, 7 June 2022 | Controls fromvalid.jpeg (file) |  |
3.6 MB | Rachel | 1 | |
| 15:53, 7 June 2022 | Labset fromvalidday.jpeg (file) |  |
2.98 MB | Rachel | 1 | |
| 15:50, 7 June 2022 | First cards.jpeg (file) |  |
3.92 MB | Rachel | 1 | |
| 15:48, 7 June 2022 | AlmostSVT.jpeg (file) |  |
3.53 MB | Rachel | 1 | |
| 05:30, 28 April 2022 | Kidsswimming@VNX.JPG (file) |  |
1.38 MB | Rachel | 1 | |
| 05:27, 28 April 2022 | SiteVNX2020.jpeg (file) |  |
899 KB | Rachel | Montreux site for monitoring | 1 |
| 16:02, 2 April 2022 | Flyer-55+Hackuairum6juin2022.jpg (file) |  |
4 MB | Rachel | 1 | |
| 15:53, 29 March 2022 | Coliscan card .jpg (file) |  |
2.63 MB | Rachel | 1 | |
| 15:02, 26 March 2022 | Pea1 closeup26mar22.jpg (file) |  |
6.35 MB | Rachel | 1 | |
| 15:00, 26 March 2022 | Pea1.jpg (file) |  |
4.13 MB | Rachel | 1 | |
| 11:08, 26 March 2022 | Infographic bes ese highlight.png (file) |  |
371 KB | Rachel | 1 | |
| 14:19, 22 March 2022 | Bilan2021b.png (file) |  |
71 KB | Rachel | 1 | |
| 11:41, 16 March 2022 | Bioartbot2.jpeg (file) |  |
204 KB | Rachel | 1 | |
| 11:37, 16 March 2022 | 160-love from your.jpg (file) |  |
523 KB | Rachel | 1 | |
| 17:31, 10 March 2022 | Fumehood2.jpeg (file) |  |
3.18 MB | Rachel | 1 | |
| 17:20, 10 March 2022 | Fumehood.jpg (file) |  |
3.08 MB | Rachel | 1 | |
| 17:14, 10 March 2022 | Shiitakea.jpg (file) | |
3.28 MB | Rachel | 1 | |
| 17:12, 10 March 2022 | Clubhousea.jpg (file) |  |
3.2 MB | Rachel | 1 | |
| 15:24, 18 February 2022 | Actualapero.JPG (file) |  |
2.07 MB | Rachel | 1 | |
| 14:52, 18 February 2022 | MoreAG22.png (file) |  |
1,005 KB | Rachel | 1 | |
| 14:50, 18 February 2022 | Estherexpliq.png (file) |  |
1.24 MB | Rachel | 1 | |
| 14:48, 18 February 2022 | Masoud expl HiSeq.png (file) |  |
688 KB | Rachel | 1 | |
| 14:42, 18 February 2022 | Esther fete.JPG (file) |  |
3.14 MB | Rachel | 1 | |
| 14:28, 18 February 2022 | Withzoom.jpg (file) |  |
3.37 MB | Rachel | 1 | |
| 14:24, 18 February 2022 | Masoud&Michel.jpg (file) |  |
3.73 MB | Rachel | 1 | |
| 14:22, 18 February 2022 | Enprésentiel.jpg (file) |  |
3.52 MB | Rachel | 1 | |
| 14:16, 18 February 2022 | AG22pano.jpg (file) | 51 KB | Rachel | 1 | ||
| 21:14, 17 February 2022 | Logoplay.png (file) |  |
26 KB | Rachel | 1 | |
| 18:02, 16 February 2022 | Likely Omicron detection by Corona Detective.jpg (file) |  |
1.31 MB | Rachel | 1 | |
| 17:52, 16 February 2022 | Bilan2021.png (file) |  |
53 KB | Rachel | 1 | |
| 15:17, 22 January 2022 | Code values logo.jpg (file) |  |
1.34 MB | Rachel | 1 | |
| 14:36, 20 January 2022 | Nkids2.jpg (file) |  |
3.1 MB | Esther | 1 | |
| 14:23, 20 January 2022 | Nkids 2027.jpg (file) |  |
3.35 MB | Esther | neurokid's workshop | 1 |
| 09:02, 20 January 2022 | SupplFigure5.jpg (file) |  |
1.39 MB | Rachel | 1 | |
| 13:54, 15 January 2022 | Aussibeach.png (file) |  |
2.15 MB | Rachel | 1 | |
| 13:49, 15 January 2022 | Mtblancdemorges.jpg (file) |  |
1.22 MB | Rachel | 1 | |
| 15:42, 8 January 2022 | Crochy20Ecublens - spaceallocupdate.png (file) |  |
2.94 MB | Rachel | 1 | |
| 15:35, 26 December 2021 | Dried scoby split.jpg (file) |  |
1.9 MB | Rachel | 1 | |
| 10:46, 25 December 2021 | Bigjump.jpg (file) |  |
4.09 MB | Rachel | 1 | |
| 10:42, 25 December 2021 | Prep4jump.jpg (file) |  |
4.13 MB | Rachel | 1 | |
| 13:30, 7 December 2021 | Scrapednuclei.PNG (file) |  |
3.47 MB | Rachel | 1 | |
| 13:23, 7 December 2021 | Screenshot from 2021-11-24 16-18-06.png (file) |  |
1.41 MB | Rachel | 1 | |
| 12:57, 7 December 2021 | Learningstudents.png (file) |  |
701 KB | Rachel | 1 | |
| 12:55, 7 December 2021 | Bench.JPG (file) |  |
3.17 MB | Rachel | 1 | |
| 12:52, 7 December 2021 | Firstcells.png (file) |  |
3.08 MB | Rachel | meblue stained | 1 |